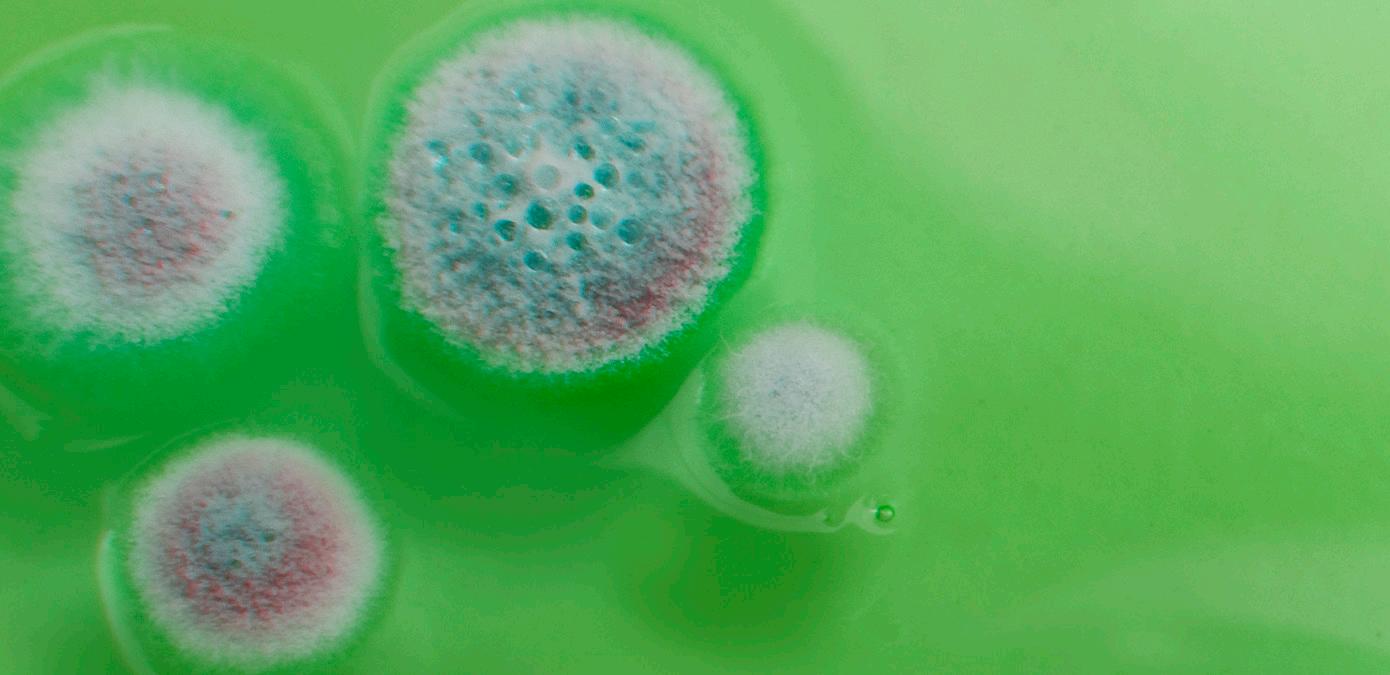

BIODETECT SYSTEM EN PRO-CLEAN
BioDetect System Effectief Gedocumenteerde Zelfcontrole van de Kwaliteit van uw Schimmelsanering








![]()
BioDetect System Effectief Gedocumenteerde Zelfcontrole van de Kwaliteit van uw Schimmelsanering








NAC Europa wil u graag danken bij deze gelegenheid voor uw interesse in ons bedrijf en onze producten. Wij zijn van mening dat het BioDetect Systeem een belangrijk instrument kan zijn in uw bedrijf voor schimmelschoonmaak en reiniging en ontsmetting na vocht- en waterschade. Het product staat u toe de kwaliteit te controleren van het werk verricht op site - het is een factor die zeer belangrijk is wanneer u en uw bedrijf beschadigde gebouwen en bouwmaterialen terug naar hun oorspronkelijke staat moet brengen, vrij van schadelijke schimmels en andere microben.
Het BioDetect systeem maakt gebruikt een gepatenteerde biochemische technologie om nauwkeurige en betrouwbare resultaten te bepalen waarmee de gebruiker de mate van biologische verontreiniging op oppervlakken kan bepalen binnen 15 seconden en tegen een aanzienlijk lagere prijs dan andere bemonsteringsmethoden.
Wij zijn er ook van overtuigd dat uw vermogen om tijd en geld te besparen tijdens saneringstaken uw markt concurrentievermogen sterk zal doen toenemen. Het BioDetect systeem geeft u een concurrentievoordeel en verbetert uw mogelijkheden om klanten te helpen met schimmel saneringstaken enz.
Aarzel niet ons te bellen via nummer +45 74 42 62 92 voor meer informatie over het BioDetect systeem of bezoek onze homepage: www.nac-europe.com.
Beste Groeten
NAC EUROPE
Jesper Natorp
Close-up van Biofilm gevonden op een oppervlak

UW TOEKOMSTIG SYSTEEM VOOR SNELLE METING VAN BIOLOGISCHE BESMETTING
I.V.M. SCHIMMEL EN WATERSCHADE ENZ.
SYSTEEM VOOR SNELLE METING VAN BIOLOGISCHE VERONTREINIGING
Het BioDetect systeem helpt saneringsbedrijven, schoonmaakbedrijven, consulting- en adviserende bedrijven, verzekeringsbedrijven enz. bij het samenstellen van analyses (schimmelschade enz.), bij het onderzoeken van schimmel- en bacteriële besmetting op waterbeschadigde materialen op een snelle, nauwkeurige en rendabele manier. De biofilms die ontstaan in verband met schimmel en bacteriële groei op water beschadigde bouwmaterialen kunnen gemakkelijk worden opgespoord met behulp van het BioDetect systeem.
De primaire functie van het BioDetect systeem is het niveau van besmetting te bepalen op bouwmaterialen en om de reinigingsen ontsmettingsdoeltreffendheid na schimmel of waterschadesanering aan te tonen.
Waterschade en schimmelgroei in gebouwen en woningen zijn ernstige gezondheidsrisico’s. Besmette of waterbeschadigde bouwmaterialen en oppervlakken in gebouwen kunnen interne luchtproblemen veroorzaken die zeer moeilijk kunnen geïdentificeerd en behandeld worden. Vaak zijn de kosten van tests, verzameling van schimmels en de werkelijke schimmelsanering enorm.
SNEL
Resultaten in 15 seconden
NAUWKEURIG
+/- 5 procent variatie
RENDABEL
Minder dan 10% van de kosten van andere testen
MAKKELIJK TE GEBRUIKEN Geen gespecialiseerde opleiding vereist
GEMAKKELIJK TE BEOORDELEN Eenvoudig numerieke display
EENVOUDIG TE BEHEREN Inclusief data management software

De BioDetect Ultrasnap ATP veegdoekjes en BioDetect Systemsure Plus luminometer worden gebruikt om het besmettingsniveau van levensvatbaar biologisch materiaal te bepalen, vooral bacterien en biofilms die aanwezig zijn op verontreinigde oppervlakken. Het doel van de bemonstering is om de mate te bepalen van de biologische oppervlakte besmetting van afgenomen substraten, bouwoppervlakken en materialen die deel uitmaken van een saneringsproject, gereinigde en ontsmette bouwmaterialen die achter zijn gelaten of waar niet werd afgenomen. De bouwmaterialen geschikt om te worden getest met het BioDetect Systeem omvatten, maar zijn niet beperkt tot, muurbouten (metaal en hout), beton, vinyl en keramische tegels, laminaat oppervlakken, roestvrij staal, metselwerk materialen, kunststof, gipsplaten, houten omhulsels, glas enz.

Het BioDetect biocontaminatie detectiesysteem is ontworpen voor evaluatie van het niveau van oppervlakte reinheid en gezuiverde hygiëne in het binnenmilieu na sanering van schimmels en bacteriën. Dit systeem zal geen specifieke soorten stammen van bacteriën, virale of andere micro-organismen opsporen, het zal eerder het totaal meten en documenteren van het hele oppervlak waar deze types van organismen kunnen worden gedetecteerd of waar ze zich bevinden als gevolg van vuil en onhygiënische omstandigheden.





METHODOLOGIE
1. Identificeer het doeloppervlak voor bemonstering (bv; muurbouten (metaal en hout), beton, vinyl en keramische tegels, laminaat, roestvrij staal, metselwerk materialen, kunststof, laminaat, gipsplaten, houten omhulsels, glas enz.)
2. Gebruik aseptische technieken voor alle monstercollectie. Verwijder de plasticdekking of buisje uit de bemonsteringsapparatuur BioDetect ATP veegdoek monstertoestel. Dit zal het veegdoekje blootstellen dat vooraf is bevochtigd om te helpen bij de monstercollectie. Zorg ervoor het doekje niet rechtstreeks aan te raken met uw vingers of hand want anders treed er een besmetting op.
3. Veeg grondig over het gewenste monsteroppervlak met een afmeting van 10 x 10 cm met ongeveer 10 lijnen verticale en 10 horizontale lijnen over het monstergebied, terwijl het staafje wordt gedraaid over het oppervlak. Het staafje kan ook worden gebruikt voor bemonstering van ontoegankelijke oppervlakken die kleiner of groter zijn dan 10 x 10 cm.
4. Na het vegen of dompelen in vloeistof plaatst u het plastic buisje terug over het veegdoekje en steek het open uiteinde terug in de kraag van het hele apparaat.
5. Grijp het uiteinde van het bolvorming object van de bemonsteringsapparatuur en de kleine kunststofstaaf in het bolvormig object. Breek daarna de module klep door het buigen van dit plastic staafje met een voorwaartse en achterwaartse beweging tot er een breuk optreed. Houdt het apparaat rechtop tijdens deze stap.
6. Knijp het bolvormig object tweemaal om het reagens te verwijderen naar beneden in het buisje van het collectiestaafje die de top van het uitstrijkstaafje bedekt.
7. Schud het apparaat grondig maar voorzichtig voor het mengen van de vloeibare inhoud in de basis van het apparaat voor ongeveer 5 seconden. Dit zorgt ervoor dat het veegdoekje goed is gewassen of ondergedompeld is in het reagens oplossing.
8. Voeg de gehele bemonsteringsapparatuur in boven aan de BioDetect Systemsure Plus luminometer. Zorg ervoor dat het apparaat volledig wordt ingevoerd in de open poort opening vóór het sluiten van het deksel van de luminometer. Het monster apparaat moet worden ingevoegd in de luminometer en moet afgelezen worden binnen 60 seconden na het breken van het module staafje. Het reagens moet geactiveerd worden zoals beschreven in stap 5), voor de meest nauwkeurige resultaten.
9. Sluit het deksel van de luminometer.
10. Druk op de knop “OK’ om de resultaten van de bemonstering te lezen. Dit proces duurt 15 seconden vanaf het moment dat u op de knop ”OK” drukt. Zorg ervoor het instrument op en neer te bewegen (verticale positie) om de beste resultaten te verkrijgen.

Veeg Breek en Knijp Voeg In Lees de Resultaten Af
Eenvoudig en makkelijk te gebruiken – gewoon vegen en breken, knijpen en meten

Oppervlakken bemonsterd waren relatief droog of kwamen in contact met water en waren bijna droog wanneer bemonsterd voor ATP.
Bemonsterde oppervlakte conditie
NORMALE SCHIMMEL ECOLOGIE
Een binnen omgeving met vastgehechte sporen, schimmelfragmenten of sporen van werkelijke groei wiens identiteit, locatie en hoeveelheid een afspiegeling zijn van een normale schimmel-ecologie voor een soortgelijke omgeving.
VASTGEHECHTE SPOREN
Een binnen omgeving die voornamelijk besmet is met vastgehechte sporen die direct of indirect verspreid worden uit een conditie 3 gebied en die wellicht sporen van werkelijke groei bevatten.
WERKELIJKE GROEI
Een binnen omgeving besmet met de aanwezigheid van werkelijke schimmel groei en bijbehorende sporen. Werkelijke groei omvat de groei die actief, slapend, zichtbaar of verborgen is.
Vocht inhoud % ATP testresultaten(RLU)
IICRC S520 conditie
1 Geslaagd
2 Opgelet 3 Niet Geslaagd
* ATP resultaten ten opzichte van conditie 1 waren afhankelijk van de totale huishoudelijke reinheid binnen de bemonsterde locatie of op de bemonsterde oppervlakte. Typische conditie 1 oppervlakken leverden ATP resultaten die varieerden van 1 RLU voor 50 RLUs; Er waren echter monsters die zo hoog waren als 150 RLUs.





Oppervlakken bemonsterd waren relatief vochtig of met een beperkt actieve vochtinval met water wanneer bemonsterd voor ATP.
Bemonsterde oppervlakte conditie
NORMALE SCHIMMEL ECOLOGIE
Een binnen omgeving met vastgehechte sporen, schimmelfragmenten of sporen van werkelijke groei wiens identiteit, locatie en hoeveelheid een afspiegeling zijn van een normale schimmel-ecologie voor een soortgelijke omgeving.
VASTGEHECHTE SPOREN
Een binnen omgeving die voornamelijk besmet is met vastgehechte sporen die direct of indirect verspreid worden uit een conditie 3 gebied en die wellicht sporen van werkelijke groei bevatten.
WERKELIJKE GROEI
Een binnen omgeving besmet met de aanwezigheid van werkelijke schimmel groei en bijbehorende sporen. Werkelijke groei omvat de groei die actief, slapend, zichtbaar of verborgen is.
Vocht inhoud % ATP testresultaten(RLU)
IICRC S520 conditie
1 Geslaagd 2 Opgelet 3 Niet Geslaagd
* ATP resultaten ten opzichte van conditie 1 waren afhankelijk van de totale huishoudelijke reinheid binnen de bemonsterde locatie of op de bemonsterde oppervlakte. Typische conditie 1 oppervlak leverde ATP resultaten die varieerden van 1 RLU voor 50 RLUs; Er waren echter monsters die zo hoog waren als 150 RLUs.
GEBRUIK VAN HET
BIODETECT TESTSYSTEEM
a) Beschadigingen of activeringen per ongeluk van het bemonsteringsapparatuur veegdoekje mag niet worden gebruikt en moeten worden verwijderd.
b) Verwijdering van het bemonsteringsapparatuur doekje kan worden gedaan in gewone afval. Geen speciale voorzorgsmaatregelen zijn vereist voor verwijdering.
c) Vermijd grote hoeveelheden van het monsterafval te verzamelen op het veegdoekje. Teveel bemonsterd materiaal kan de signaalsterkte beperken van de test en onnauwkeurige lezingen of valse negatieven opleveren.
d) Houd de BioDetect Systemsure Plus rechtop tijdens stap 10).
e) Houd het BioDetect Ultrasnap ATP apparaat rechtop tijdens activatie in stap 5).
f) Het BioDetect Ultrasnap ATP veegdoekje weerstaat kamertemperatuur opslag voor maximaal twee maanden maar alle ongebruikte bemonstering apparaten moeten worden opgeslagen in de koelkast waar zij levensvatbaar zijn voor maximaal 12 maanden.
















SNELLE EIWIT RESIDU TEST
PRO-Clean is een snelle en gemakkelijke manier om nauwkeurig de reinheid te controleren van oppervlakken voor het verzekeren van productkwaliteit. PRO-Clean detecteert eiwit residuen achtergebleven op een oppervlak na het schoonmaken. Neem gewoon een monster van het oppervlak, breng het reagens aan en als er eiwit residu aanwezig is, kleurt het reagens paars.
De kleurverandering biedt een semi-kwantitatieve weergave van de oppervlakte reinheid. Hoe meer verontreiniging aanwezig, hoe sneller de kleur wijzigt in paars en hoe donkerder de kleur. PRO-Clean valideert snel de hygiëne van een oppervlak en staat onmiddellijke corrigerende actie toe indien nodig.






